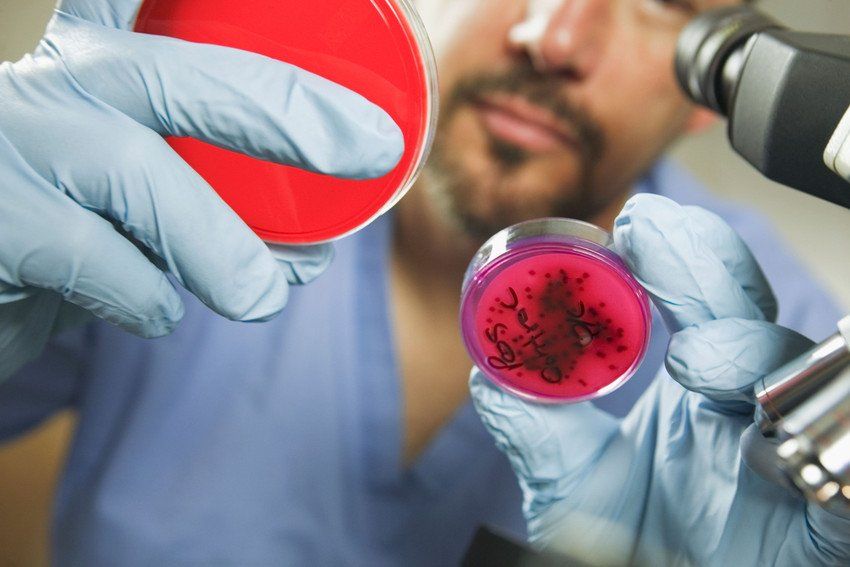

AN INNOVATIVE AND PROFESSIONAL SERVICE - EXPERT WATER HYGIENE SERVICES ACROSS london & Kent
Protect your business from Legionella outbreaks and ensure water hygiene compliance with the team at Stonegrove FM Ltd. Working across London & Kent, we can create practices that maintain and manage the health of your water systems, including water supplies, air handling units, domestic water systems supplying showers, or any fixture where an aerosol can be generated. Tailored to meet your organisation’s needs, our water hygiene services ensure compliance with current legislative and regulatory requirements.
We complete our proactive maintenance programmes and remedial works in accordance with ACOP L8 (2013) HSG274 and Legionella Control Association standards.
LCA CERTIFICATE
CODE OF CONDUCT
We complete our proactive maintenance programmes and remedial works in accordance with ACOP L8 (2013) HSG274 and Legionella Control Association standards.
KITCHEN MAINTENANCE
We offer a range of kitchen maintenance services to help you adhere to set compliance standards.
HEATING VENTILATION & AIR CONDITIONING
Stonegrove offers a full range of heating, ventilation and cooling services. Contact us for more information about how we can help meet your needs.
PROUD MEMBERs OF THE LEGIONELLA CONTROL ASSOCIATION
Here at Stonegrove FM Ltd, we have been members of the Legionella Control Association since 2016. We liaise with the LCA to ensure you remain compliant with their Water Hygiene Management Programmes. As a member of the LCA, you can be sure that we are delivering the best and most up to date practices for your business. Stonegrove FM Ltd is externally audited annually, ensuring that we meet the strict LCA code of membership.
CONTACT US
OTHER WATER HYGIENE SERVICES
- Cleaning and Disinfection Services - Stonegrove Group provides a descaling and cleaning service in accordance with PPM maintenance scheduling. Whether you need routine descaling for shower heads and taps or Calorifier condition inspections and ultrasonic cleans, our fully trained team can deliver a range of bespoke solutions.
- Legionella Analytical Services - We have over 25 years of experience when it comes to bacterial testing and analysis on cold water, domestic hot water and closed water circuits. We provide routine monitoring of biocide levels and microbiological parameters and monthly temperature testing and logging. All our monitoring services are completed by independent UKAS labs.
- Plant and Equipment Services - We provide a comprehensive range of specialised plant and equipment services. These include TMV adjustments and servicing, Calorifier maintenance and inspections, installation of new water heaters, cutting back of dead legs, modifications to CWS tanks, modifications to water systems, disinfection of CWS tanks and water systems, conversions of tanks to mains water supplies and installation of new water heaters.
OUR FULLY TRAINED WATER HYGIENE TEAM
At Stonegrove FM Ltd, our team is fully trained to deliver water hygiene services. Each member of our team is aware of potential risks and can negate and navigate them effectively for you. We also provide training services for your team, including:
- Client training on legionella awareness
- Practical water hygiene maintenance training
- Allocation of site summary plans
- Assisting clients to build bespoke water hygiene management structures
- Implementation of written water hygiene management schemes
SAFE, SECURE AND EFFICIENT PRACTICE - THOROUGH LEGIONELLA RISK ASSESSMENTS FOR CLIENTS ACROSS KENT AND LONDON
As members of the Legionella Control Association since 2016, Stonegrove FM Ltd understands the importance of thorough legionella risk assessments. Providing fully compliant services across London & Kent, we ensure that your systems conform to Water Hygiene Management Programmes.
OUR SERVICES ARE DELIVERED TO THE HIGHEST STANDARDS
Stonegrove FM Ltd undertakes legionella risk assessments of hot & cold-water systems in accordance with the HSE’s Approved Code of Practice L8 (4th Edition) & Technical Guidance HSG274 (Parts 2 & 3) & BS8580:2010. Our risk assessment services include:
- Asset list & basic water system schematic drawings (includes identification of dead-leg, blind end pipes & infrequently used outlets)
- Control measures scheme & remedial action summary
- All risk assessors are qualified and experienced with strong building/engineering backgrounds.
FULLY COMPLIANT LEGIONELLA TRAINING ACROSS London & kent
Is your team aware of the potential risks of legionella and what to do if they occur?
At Stonegrove FM Ltd, our team can give your staff the practical training they need to navigate water hygiene situations. Providing safe, secure, and efficient services, we empower your business to take action on legionella and water maintenance.
At Stonegrove FM Ltd, our team can give your staff the practical training they need to navigate water hygiene situations. Providing safe, secure, and efficient services, we empower your business to take action on legionella and water maintenance.
PROFESSIONAL TRAINING FOR KENT AND LONDON ORGANISATIONS
At Stonegrove FM Ltd, we can provide the professional and trusted water hygiene and legionella training that you need. With more than 25 years of industry experience, we will tailor our training to meet your requirements. Our training includes detailed site summary plans and assistance building tailored water hygiene management structures. Our legionella training will also equip you with:
- General legionella knowledge and awareness
- Practical water hygiene maintenance training
- The implementation of written water hygiene management schemes
To find out more about our LCA training programmes , speak with an expert member of our team today or use our online enquiry form.
020 3319 9314
Email: dave@sggrouplondon.co.uk
Stonegrove FM Ltd, 1st Floor & 2nd Floor, 84-86 High Street, Rainham, Kent, ME8 7JH
Email: dave@sggrouplondon.co.uk
Stonegrove FM Ltd, 1st Floor & 2nd Floor, 84-86 High Street, Rainham, Kent, ME8 7JH
Our company ethos is to bring safe, secure and efficient practice to works completed for our clients. Our company goal is to offer a committed, thorough service to all of our customers by utilising the skill set of our workforce.
Our key principles as a business:
Passion Professionalism Commitment Aspirational